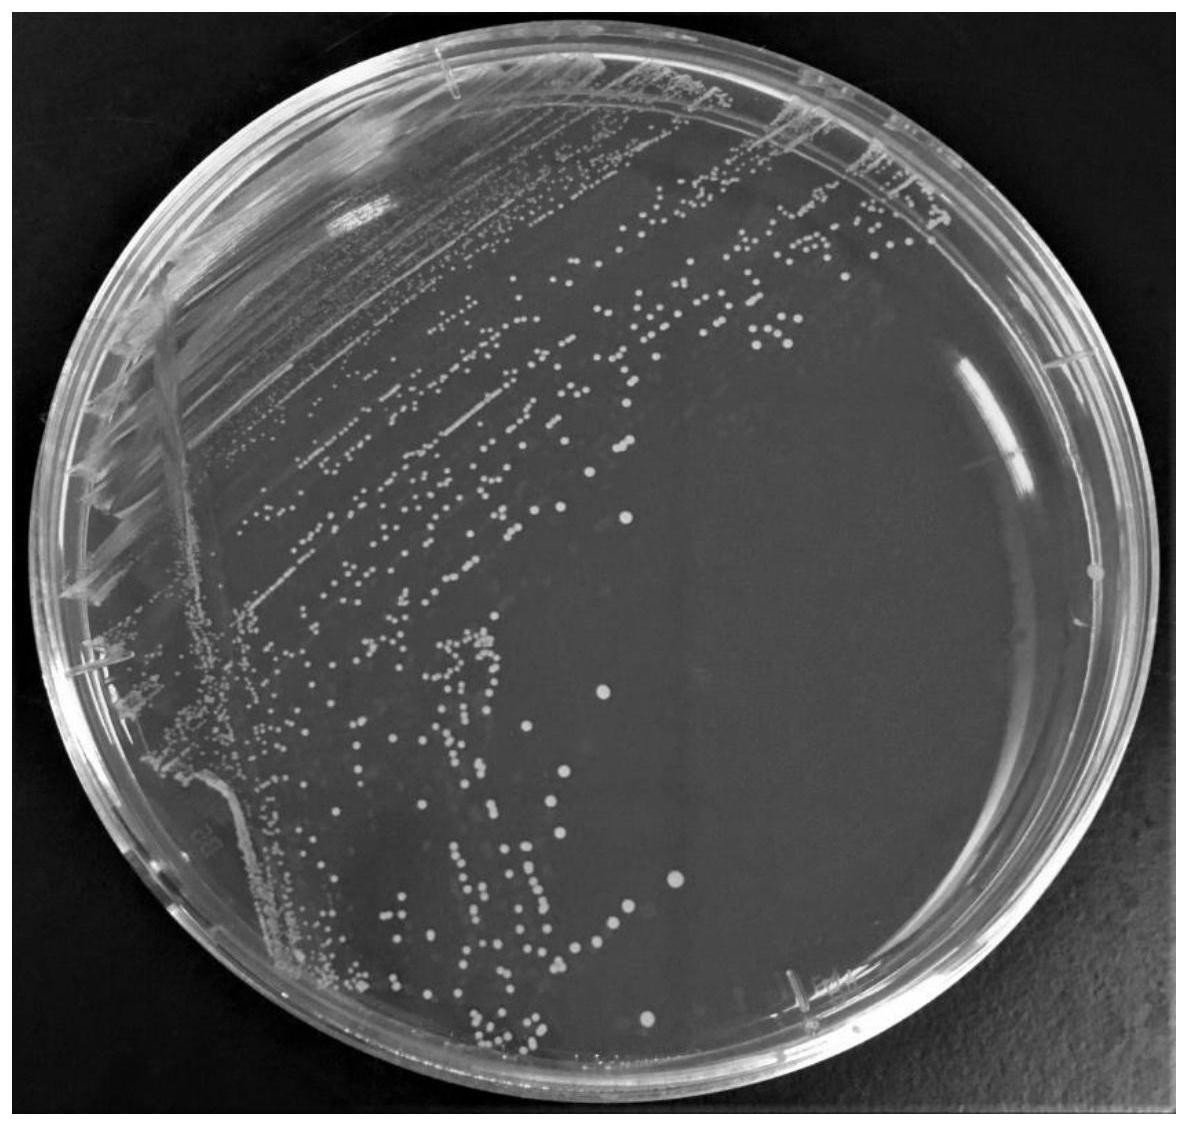
一种乳酸菌组合物及其应用

乳酸菌细胞图片

南方科技大学 显微镜下的乳酸菌
图片尺寸1200x675
这四种都是什么乳酸菌
图片尺寸885x660
乳酸菌在水产养殖中的七大功效解毒促生长广谱抗菌生态灭弧菌
图片尺寸400x399乳酸菌的细菌
图片尺寸1100x1100
真菌细胞.这是乳酸乳球菌,常被用来制作奶酪.
图片尺寸516x600
生物揭秘科学探究系列之观察乳酸菌
图片尺寸640x475
一种乳酸菌组合物及其应用
图片尺寸1187x1127
乳酸乳球菌乳脂亚种
图片尺寸800x600
细菌乳酸菌革兰氏阳性棒状乳酸菌.
图片尺寸700x467
显微镜下乳酸菌培养过程中乳酸菌的亮团短视频
图片尺寸580x326
澳优在国际乳业顶级期刊发表论文,分享人乳源乳酸菌筛选评价结果
图片尺寸1650x658
乳酸菌在水产养殖中的七大功效解毒促生长广谱抗菌生态灭弧菌
图片尺寸400x395
一种乳酸片球菌及其用途制造技术
图片尺寸1000x945乳酸链球菌细菌
图片尺寸1200x800
细胞多样性与统一性2.ppt
图片尺寸1152x864益生菌乳酸菌
图片尺寸1200x800
培养24 h,其生长情况及革兰氏染色观察菌体细胞的形态特征如图2所示
图片尺寸632x349
亩成本不到5毛通威乳酸菌高温扩培方案
图片尺寸1080x496
乳酸菌(左)双歧杆菌(右)
图片尺寸900x446
提高教学效率 1,泡菜制作基础知识 (1)乳酸菌 种类:常见的乳酸菌有
图片尺寸1080x810
猜你喜欢:青霉菌细胞图片肺炎双球菌细胞图片毛霉细胞图片叶肉细胞图片表皮细胞图片乳酸菌结构图平滑肌细胞图片口腔上皮细胞图片酵母菌细胞图片乳酸菌细胞结构图工作细胞乳酸菌图片乳酸菌图片乳饮料乳酸菌图片结构图乳酸菌细胞乳酸菌图片工作细胞乳酸菌工作细胞红细胞图片草莓乳酸菌图片乳酸菌图片卡通乳酸杆菌图片蓝莓乳酸菌图片娃哈哈乳酸菌图片芒果乳酸菌图片乳酸菌图片显微镜工作细胞乳酸菌高清工作细胞乳酸菌壁纸工作细胞乳酸菌头像乳酸菌显微镜下图片工作细胞细菌图片大全细胞图片铆钉衣服图片吴刚神话李知恩胖的图片奶茶包装盒Valleygirl几米抱抱图片lol伊芙琳皮肤象棋战术努力的刘刘荔枝包装白黄鼠狼恐怖无所谓图片 表情包